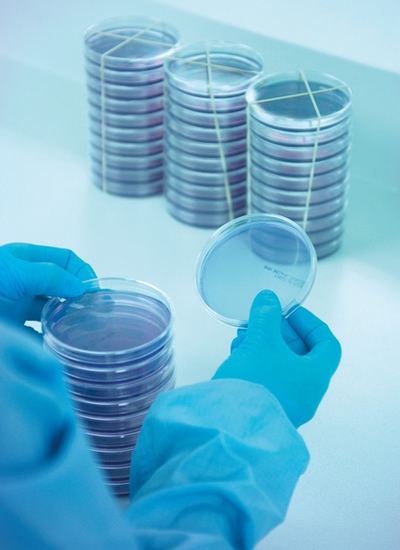

In pharmaceutical manufacturing, quality control is of the utmost importance; requiring a combination of tests, protocols and validated processes to minimise risk to public health. Sterility testing is recognised as a key step in ensuring pharmaceutical products are free from the presence of viable microorganisms and safe for human use at the final point before release. However, sterility testing has come under fire since its inception in 1932, as it is not perfect and should not be used as a standalone guarantee of sterility.
The key issue is that sterility testing can only detect microorganisms that will grow in the medium and conditions used in a particular test. Therefore, the test should be devised to provide ideal conditions for the most likely potential contaminants within an individual facility, so that it can be a reliable indicator of process failure.
A continuous EM programme will deliver far better insights into the hygiene of a facility, informing future precautionary measures
Another concern is the statistical nature of the sterility test. A negative test can only prove the sterility of a single sample, yet the result must be extrapolated from an entire batch. Plus, if a positive result is recorded, despite it only being found in a single sample, the whole batch will be quarantined at great expense. Any contamination must be thoroughly investigated, potentially causing serious consequences to productivity and cost implications within the broader business.
So, how can organisations ensure the integrity of their pharmaceutical product manufacture and mitigate the risk of sterility test failure? It all starts with facility design and validation and requires good operator training, well-designed processes, and well-considered environmental monitoring (EM) protocols, including particle monitoring.
Inadequacies in sterility testing
The sterility test still remains the best available quality control measure for assessing a sterile aseptic process and the microbial safety of the final product. However, it should really be regarded as just the final step in a series of protocols that all play a vital part in minimising and identifying any contamination of pharmaceutical products.
Such an approach on quality assurance is crucial when considering the limitations of the sterility test, as previously discussed, but also in certain pharmaceutical production situations that may arise, where sterility testing cannot be completed before administration due to the nature of the medication and/or the urgency of need by the patient.
An EM programme must also comprise different monitoring techniques and ideally be an ongoing, continuous exercise
Take prescribed medication for example. If the medicine is needed within 14 days, sterility testing is invalid because it takes at least 14 days to carry out. This is also the case in hospital pharmacies and private commercial enterprises that manufacture medicinal products to order for immediate or short notice patient use. Problems also arise with antimicrobial medication since it is designed to eradicate microbes, so the product itself will prevent microbial growth and invalidate the test. Consequently, the best way of ensuring the sterility of a final product is by assuring that the sterility of the conditions in which it is manufactured are at the desired standard.
Continuous environmental monitoring
Continuous environmental monitoring gives constant insight into microbial levels throughout a manufacturing facility.
Plate checking at Cherwell
Contamination can happen from any one of multiple potential sources. So, if a sterility test shows a positive contamination result, EM data can also help narrow down the cause very quickly; but only if EM processes are sound.
There are several considerations to ensure that an EM programme and sterility testing maintain safety throughout production. An EM programme must focus on collecting data consistently and accurately if it is going to help to mitigate risks effectively. If contamination occurs, then the data gleaned from the EM becomes critical in the subsequent investigation.
An EM programme must also comprise different monitoring techniques and ideally be an ongoing, continuous exercise. Such an approach significantly reduced the length of an investigation because it can help pinpoint with precision the areas at highest risk and enable procedural tests to be conducted in a very targeted way.
The monitoring techniques used in an EM programme should include particle monitoring, active air sampling, with settle or exposure plates, surface contact plates or swabs, and operator finger dabs. This ensures that there is EM data for both viable and non-viable monitoring results, which can prove invaluable in identifying the root cause of contamination and reduce disruption to production.
Preventing sterility test failures
A continuous EM programme will deliver far better insights into the hygiene of a facility, thereby informing future precautionary measures. Since the best defence is a good offence, taking a pro-active stance towards maintaining the sterility of an entire facility is the best weapon against any possible future sterility test failure.
It is important that EM programmes are monitoring and gathering data from both the test room facility as well as the testing environment, such as a unidirectional airflow isolator. Even if sterility testing has so far proved negative, there are no guarantees that all future tests will go the same way.
A well-designed EM programme will reveal any shift in the trend of microbial levels
A well-designed EM programme will reveal any shift in the trend of microbial levels, enabling the prediction of increased risks and inform accordingly of areas where greater attention to the sterility protocol is required.
The core idea behind continuous EM is to prevent any future sterility test failure before it can happen and remove as much risk of contamination as possible. A robust EM programme can reveal a potential contamination problem before it can impact a sterility test. It can also make a facility even safer by detecting early issues that a one-off sterility test might not necessarily detect. Ultimately, if a sterility test fails, then the EM programme has also failed, and ultimately, impact the product quality and business reputation.
Beyond air samples

A checklist to help minimise
positive sterility test results
An EM programme must cover all areas and processes within a facility. This is to ensure that in the case of a sterility test failure there is data available to prove that the rest of the facility is sterile and met all necessary safety standards at the time of the test failure.
Effective environmental monitoring is not only about collecting air samples. It should be proved that a programme has assessed potential risks and includes the monitoring of filling areas, operator effectiveness and the behaviour of the personnel concerned. For this reason, it should be ensured that when assessing an EM process and facility, it includes daily disinfection, deep decontamination procedures, staff training and equipment calibration records. Being able to provide this information in the event of an investigation allows a facility to be up and running again far more quickly than if all areas and protocols need to be checked and tested from scratch.
Final considerations
Having a clear idea of the type of EM programme a particular facility requires is critical to achieving sterility. A combination of settle plates and air samplers is recommended for continuous environmental monitoring, and it is important to ensure they are placed precisely for optimum data gathering at critical areas of a facility. A full annual audit should also be undertaken on all monitoring processes and aligned with the latest regulations.
As discussed, the sterility test is one of the most widely used and well-established processes within the pharmaceutical industry; however, there is certainly a need for aspects to be adapted in certain situations.

Settle plates
As pharmaceutical products and their manufacturing techniques continue to evolve, there is an increasing need for bespoke formulations of testing media and method validation. Therefore, to be as effective as possible, it is becoming more important for pharmaceutical businesses to seek tailor-made solutions for their changing needs.
Developing the right testing media for method validation can take some experimentation. So now, it is also important for manufacturers to nurture flexible, agile service relationships with their suppliers who can support and advise them in their testing needs.
For a more in-depth look at sterility testing and how to best avoid the risk of test failures, Cherwell has published the eBook "Failure is not an option: Why sterility testing is so important". It is available to download from Cherwell's website.
N.B. This article is an edited version of the article featured in the November 2019 issue of Cleanroom Technology.
Subscribe today and get your print copy! The latest digital edition is available online.